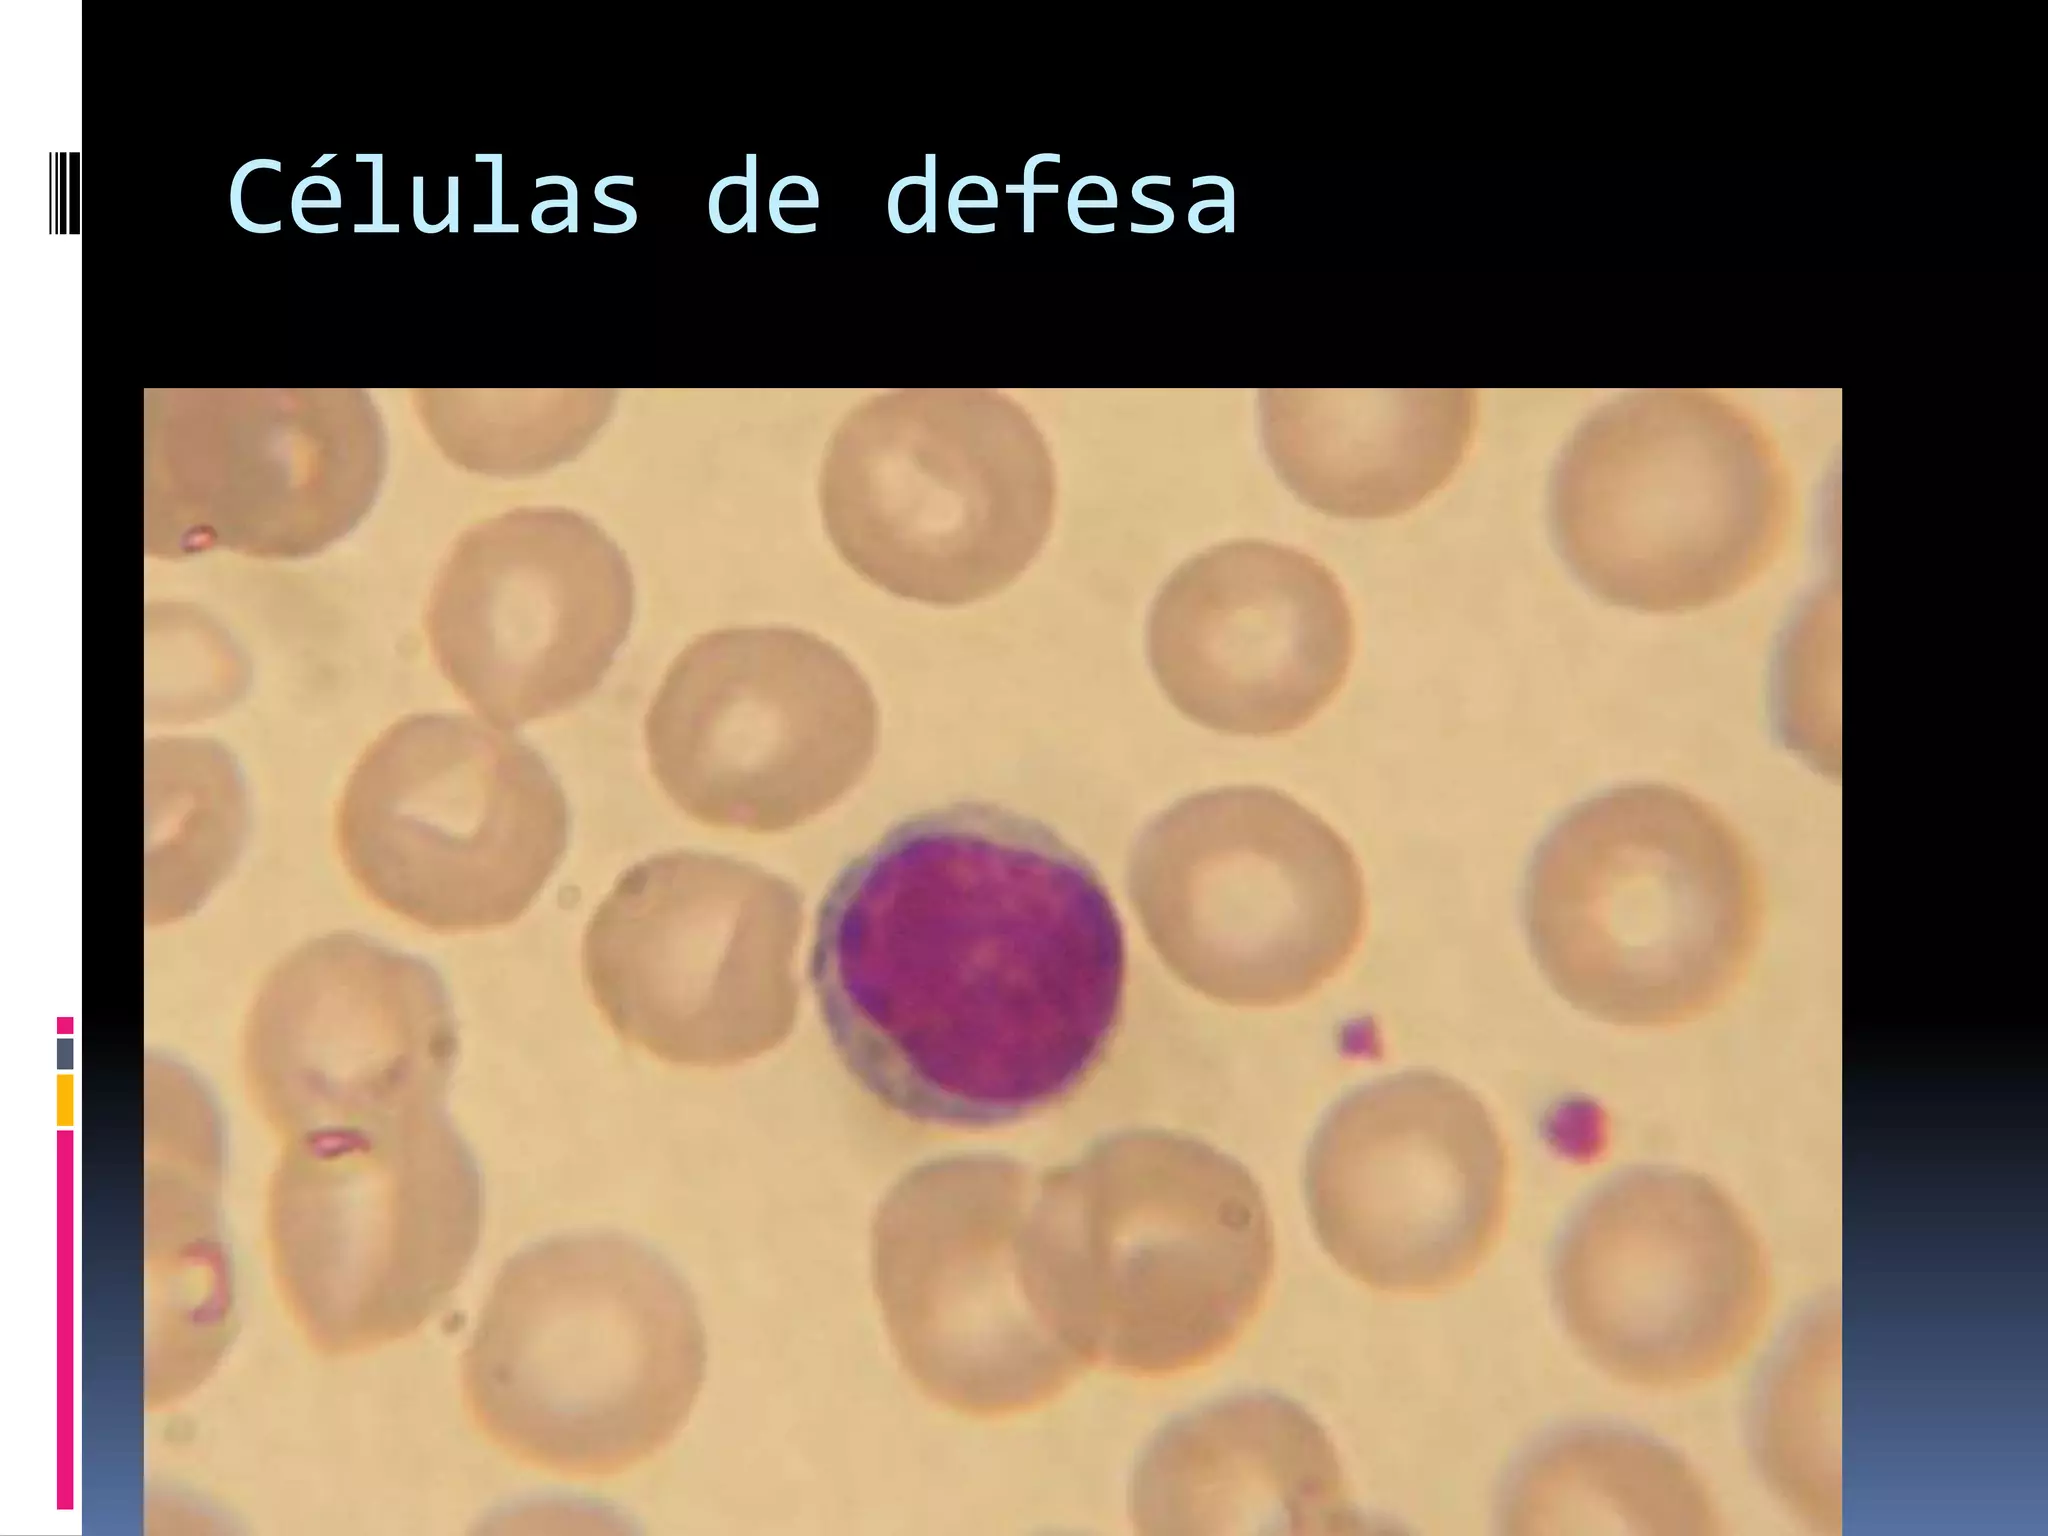
Células de defesa

Incorporar apresentação
















O documento descreve as funções do sistema linfático e imunológico, incluindo drenar o excesso de líquido dos tecidos, absorver gordura e produzir células imunes. Também explica que o sistema imunológico defende o organismo contra invasores, remove células anormais e mortas, e é composto por células de defesa, imunoglobulinas, linfócitos que combatem invasores, e propriedades de proteção.